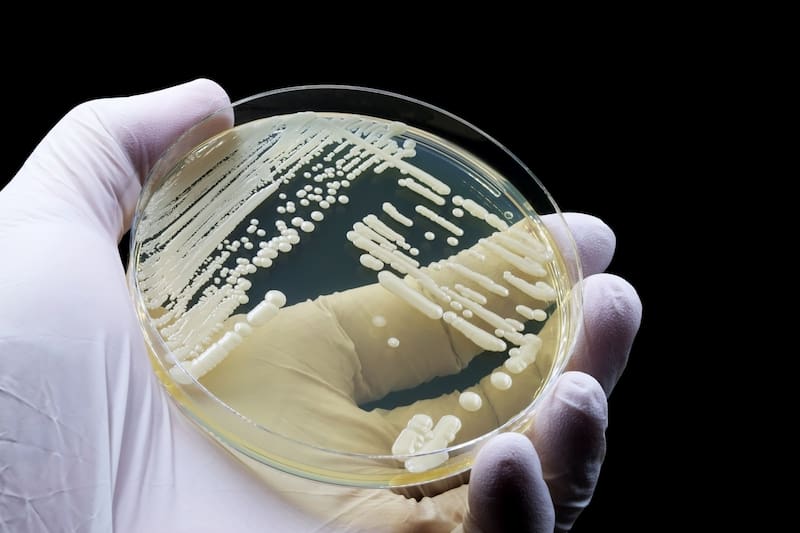
Científicos descubren una planta que produce oro puro: es muy común y se puede cultivar en casa. Fuente: Archivo

Desde la antigüedad, la humanidad ha soñado con convertir materiales comunes en oro. Esta aspiración, que dio origen a leyendas como la piedra filosofal, ahora podría estar más cerca de lo real gracias a un hallazgo científico reciente. Un grupo de investigadores descubrió que un hongo, presente de forma natural en muchos entornos y cultivable en casa, tiene la capacidad de producir oro puro a partir de compuestos minerales.
El descubrimiento fue liderado por el equipo de la Commonwealth Scientific and Industrial Research Organisation (CSIRO) en Australia, y se publicó en la revista científica Nature Communications.
El estudio abre una vía completamente nueva en la obtención del oro, al demostrar que no se necesitan grandes explotaciones ni maquinaria pesada, sino la acción de un organismo vivo. El protagonista: el Fusarium oxysporum, un hongo conocido por afectar a ciertas plantas, pero ahora reconocido por un poder oculto que cambia por completo su imagen.

¿Qué es el Fusarium oxysporum, el hongo que produce oro?
El Fusarium oxysporum es un hongo ampliamente distribuido en suelos de todo el mundo. Hasta ahora era temido por los agricultores por su capacidad para dañar cultivos como el tomate o el plátano. Sin embargo, la ciencia acaba de descubrirle una habilidad asombrosa: puede transformar minerales en partículas de oro.
Este hongo es capaz de absorber metales como hierro, aluminio y calcio, y en el proceso, formar nanopartículas de oro en su superficie, explica el investigador Tsing Bohu, líder del experimento. Para comprobarlo, lo expusieron a polvo mineral extraído de un meteorito proveniente del cinturón de asteroides. La reacción biológica no sólo fue visible, sino medible a nivel microscópico.
Este fenómeno se encuadra en lo que se conoce como ciclo biogeoquímico del oro, un proceso natural en el que ciertos organismos intervienen en la formación y acumulación de este metal precioso en la corteza terrestre.
¿Cómo convierte oro un hongo común?
A diferencia de otros métodos de obtención del oro que requieren calor, presión y productos químicos contaminantes, el proceso del Fusarium oxysporum es completamente biológico. Según el estudio, este hongo genera enzimas que modifican el entorno mineral, facilitando que el oro en forma de iones se precipite y se acumule nuevamente como oro sólido.
Los investigadores observaron que este proceso se repite en presencia de determinadas sales minerales, lo que sugiere que el hongo reconoce las partículas de oro y actúa sobre ellas de forma dirigida. "El comportamiento del Fusarium es clave para entender cómo se forma el oro en la naturaleza, y puede aprovecharse para replicar ese proceso", detallaron desde CSIRO.
Además, encontraron que los hongos del orden Hypocreales, al que pertenece el Fusarium, son más abundantes en zonas con alto contenido aurífero, lo que refuerza la idea de que estos organismos cumplen un rol central en la bioprecipitación del metal.
¿Se puede cultivar en casa un hongo que fabrica oro?
Aunque pueda parecer ciencia ficción, la respuesta es sí. En teoría, cualquier persona que cuente con un entorno estéril y ciertos minerales podría replicar este proceso en su casa o laboratorio casero. El hongo Fusarium oxysporum no necesita instalaciones industriales ni reactores complejos, lo que lo convierte en un candidato ideal para desarrollos domésticos o de pequeña escala.
Este avance se inscribe en un campo emergente llamado minería metabólica, que estudia cómo aprovechar microorganismos para extraer minerales valiosos sin dañar el ambiente. Es una alternativa limpia, sin explosiones, sin uso intensivo de agua, y sin montañas de residuos.
"En condiciones controladas, el hongo puede generar pequeñas cantidades de oro. Es un enfoque revolucionario", indicó Bohu.
El futuro de la minería podría estar en los hongos (y en el espacio)
Más allá del impacto ambiental positivo, esta técnica podría abrir la puerta a la extracción de recursos en otros planetas. De hecho, el hongo fue capaz de procesar polvo de un meteorito, lo que indica que su uso en misiones espaciales no está fuera de la agenda científica.
De acuerdo con la base de datos Asterank, existen asteroides cercanos a la Tierra con recursos valorados en más de 1500 millones de dólares. Si un organismo como el Fusarium puede transformar ese material en oro, se estaría frente a una herramienta clave para el futuro de la minería espacial.
En paralelo, se investiga cómo aumentar el rendimiento del hongo mediante ingeniería genética, y si puede adaptarse a distintos sustratos y condiciones ambientales. En otras palabras, la industria ya mira con atención la posibilidad de convertir a estos microorganismos en fábricas vivas de oro.